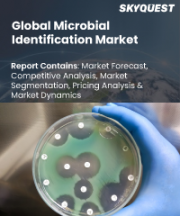

|
시장보고서
상품코드
1897856
미생물 동정 시장 규모, 점유율, 성장 분석 : 제품 및 서비스별, 방법별, 기술별, 용도별, 최종사용자별, 지역별 - 업계 예측(2026-2033년)Microbial Identification Market Size, Share, and Growth Analysis, By Product & Service (Instruments & Software, Consumables, Panels/Id Cards & Media), By Method, By Technology, By Application, By End User, By Region - Industry Forecast 2026-2033 |
||||||
세계의 미생물 동정 시장 규모는 2024년에 50억 6,000만 달러로 평가되며, 2025년 56억 9,000만 달러에서 2033년까지 144억 9,000만 달러로 성장할 전망입니다. 예측 기간(2026-2033년)의 CAGR은 12.4%로 예측됩니다.
세계 미생물 동정 시장은 감염성 질환 증가 추세와 분자진단 기술의 발전에 힘입어 진단학 및 미생물학 분야에서 매우 중요한 분야를 형성하고 있습니다. 세계화, 도시화, 기후 변화 등의 요인이 효과적인 미생물 식별 기술에 대한 수요 증가에 기여하고 있습니다. 차세대 시퀀싱, PCR, 질량분석 등의 혁신 기술은 정확도와 속도를 향상시켜 시장 확대를 촉진하고 있습니다. 보건기관의 인식 제고와 지원 강화는 감염병 대책의 중요성을 부각시키고 관련 시책에 필요한 자금과 자원을 확보하는 데 기여하고 있습니다. 그러나 높은 초기 비용, 복잡한 미생물 동정 절차, 엄격한 규제 요건 등의 문제가 시장 성장을 저해할 수 있으며, 특히 개발도상국에서는 이러한 문제들이 시장 성장을 저해할 수 있습니다. 그럼에도 불구하고 현장 진료 검사의 발전, AI 통합, 신흥 연구 시장 수요 증가와 함께 성장 기회는 계속되고 있습니다.
세계 미생물 동정 시장 성장 촉진요인
식중독 및 감염성 질환의 발생률이 증가함에 따라 엄격한 식품 안전 프로토콜의 중요성이 커지고 있습니다. 그 결과, 규제 당국은 식품 생산자와 제조업체에 엄격한 미생물 검사 기준과 관행의 시행을 강력히 요구하고 있습니다. 식품 안전에 대한 관심이 높아지면서 식품 및 음료 분야 시장 확대가 가속화되고 있습니다. 기업은 이러한 안전 요구사항에 대응하기 위해 종합적인 미생물 식별 기술 도입에 더욱 주의를 기울이고 있으며, 이는 세계 미생물 식별 시장의 혁신과 성장을 가속하고 있습니다. 식품 안전 조치를 개선하기 위한 지속적인 노력은 업계의 관행을 지속적으로 형성하고 시장의 발전을 주도하고 있습니다.
세계 미생물 동정 시장 성장 억제요인
미생물의 동정 및 특성 평가는 전문적인 지식과 기술을 필요로 하는 중대한 과제가 존재합니다. 이러한 본질적인 복잡성은 특히 자원이 부족하고 기술 훈련이 부족한 지역에서 많은 연구소와 의료 서비스 프로바이더들이 첨단 시스템 및 기술 도입을 주저하게 만드는 요인이 됩니다. 결과적으로 첨단 툴에 대한 접근성 부족과 숙련된 인력의 부족은 이 분야의 혁신 기술의 보급과 활용을 저해할 수 있으며, 전 세계 미생물 동정 시장의 성장을 저해할 수 있습니다. 따라서 성장을 가속하고 미생물 동정 실습을 개선하기 위해서는 이러한 장벽을 극복하는 것이 필수적입니다.
세계 미생물 동정 시장 동향
세계 미생물 동정 시장에서는 차세대 시퀀싱, 중합효소연쇄반응(PCR) 등의 기술 발전을 배경으로 신속 분자진단법의 채택이 두드러진 추세입니다. 이러한 전환은 병원균의 신속하고 정확한 식별 필요성을 강조하며, 의료진이 적시에 정보에 입각한 치료 결정을 내릴 수 있도록 돕습니다. 이러한 분자 기술은 기존 배양 기반 방식에 비해 우수한 민감도와 빠른 결과 제공으로 조기 진단을 통해 환자의 치료 결과를 향상시킬 수 있습니다. 의료 분야가 정밀의료를 우선시하고 진단 효율을 지속적으로 향상시키는 가운데, 혁신적인 미생물 식별 솔루션에 대한 수요가 크게 증가하여 시장 상황을 변화시킬 것으로 예측됩니다.
자주 묻는 질문
목차
서론
- 조사의 목적
- 정의
- 시장 범위
조사 방법
- 정보 조달
- 2차 데이터 및 1차 데이터 정보원
- 시장 규모 예측
- 시장의 전제조건과 제한
개요
- 전망
- 공급 수요 동향 분석
- 부문별 기회 분석
시장 역학과 전망
- 시장 역학
- 촉진요인
- 기회
- 억제요인
- 과제
- Porter의 산업 분석
주요 시장 인사이트
- 기술 분석
- 밸류체인 분석
- 시장의 에코시스템
- 공급망 분석
- 사례 연구 분석
- 규제 상황
- 혁신 매트릭스
- 주요 투자의 분석
- 주요 성공 요인
- 경쟁의 정도
미생물 동정 시장 : 제품·서비스별
- 기기·소프트웨어
- 소모품
- 패널/ID 카드 및 배지
- 키트
- 기타 소모품
- 서비스
미생물 동정 시장 : 방법별
- 표현형법
- 단백질체학 기반 방법
- 유전자형법
미생물 동정 시장 : 기술별
- 질량분석법 기반 미생물 동정 시장
- PCR 기반 미생물 동정 시장
- 유세포분석 기반 미생물 동정 시장
- 현미경법 기반 미생물 동정 시장
- 기타 미생물 동정 기술
미생물 동정 시장 : 용도별
- 진단 용도
- 인간 질환 진단
- 동물 질병 진단
- 의약품 용도
- 식품 검사
- 음료 검사
- 화장품 및 퍼스널케어 제품 시험
- 환경 분야 응용
- 기타 용도
미생물 동정 시장 : 최종사용자별
- 병원, 진단 검사실 및 혈액은행
- 제약회사 및 수탁조사기관
- 식품 제조 회사
- 음료 제조 회사
- 기타 최종사용자
미생물 동정 시장 : 지역별 시장 규모 :
- 북미
- 미국
- 캐나다
- 유럽
- 독일
- 스페인
- 프랑스
- 영국
- 이탈리아
- 기타 유럽 지역
- 아시아태평양
- 중국
- 인도
- 일본
- 한국
- 기타 아시아태평양
- 라틴아메리카
- 브라질
- 기타 라틴아메리카 지역
- 중동 및 아프리카(MEA)
- GCC 국가
- 남아프리카공화국
- 기타 중동 및 아프리카
경쟁 구도
- 상위 5사의 비교
- 주요 기업의 시장 포지셔닝(2025년)
- 주요 시장 기업이 채택한 전략
- 시장에서의 최근 활동
- 주요 기업의 시장 점유율(2025년)
주요 기업 개요
- BioMerieux SA(France)
- Becton, Dickinson and Company(BD)(US)
- Thermo Fisher Scientific Inc.(US)
- Danaher Corporation(US)
- Merck KGaA(Germany)
- Bruker Corporation(US)
- Shimadzu Corporation(Japan)
- Qiagen NV(Netherlands)
- Avantor, Inc.(US)
- Accelerate Diagnostics, Inc.(US)
- Biolog, Inc.(US)
- Liofilchem S.r.l.(Italy)
- Trivitron Healthcare(India)
- Gradian Diagnostics(US)
- Alifax S.r.l.(Italy)
- HiMedia Laboratories(India)
- i2a SA(France)
- Zhuhai DL Biotech Co., Ltd.(China)
- GeneFluidics, Inc.(US)
- Creative Diagnostics(US)
Global Microbial Identification Market size was valued at USD 5.06 Billion in 2024 and is poised to grow from USD 5.69 Billion in 2025 to USD 14.49 Billion by 2033, growing at a CAGR of 12.4% during the forecast period (2026-2033).
The global microbial identification market represents a crucial sector within diagnostics and microbiology, driven by an increasing prevalence of infectious diseases and advancements in molecular diagnostics. Factors such as globalization, urbanization, and climate change contribute to rising demand for effective microbial identification technologies. Innovations like next-generation sequencing, PCR, and mass spectrometry enhance accuracy and speed, further propelling market expansion. Increased awareness and support from health organizations highlight the importance of controlling infectious diseases, leading to necessary funding and resources for relevant initiatives. However, challenges such as high initial costs, complexity in microbial identification procedures, and stringent regulatory requirements could hinder market growth, particularly in developing regions. Nevertheless, growth opportunities emerge through advancements in point-of-care testing and AI integration, coupled with rising demand in emerging research markets.
Top-down and bottom-up approaches were used to estimate and validate the size of the Global Microbial Identification market and to estimate the size of various other dependent submarkets. The research methodology used to estimate the market size includes the following details: The key players in the market were identified through secondary research, and their market shares in the respective regions were determined through primary and secondary research. This entire procedure includes the study of the annual and financial reports of the top market players and extensive interviews for key insights from industry leaders such as CEOs, VPs, directors, and marketing executives. All percentage shares split, and breakdowns were determined using secondary sources and verified through Primary sources. All possible parameters that affect the markets covered in this research study have been accounted for, viewed in extensive detail, verified through primary research, and analyzed to get the final quantitative and qualitative data.
Global Microbial Identification Market Segments Analysis
Global Microbial Identification Market is segmented by Product & Service, Method, Technology, Application, End User, and region. Based on Product & Service, the market is segmented into Instruments & Software, Consumables, and Services. Based on Method, the market is segmented into Phenotypic Methods, Proteomics-Based Methods, and Genotypic Methods. Based on Technology, the market is segmented into Mass Spectrometry-Based Microbial Identification Market, PCR Based Microbial Identification Market, Flow Cytometry Based Microbial Identification Market, Microscopy Based Microbial Identification Market, and Other Microbial Identification Technologies. Based on Application, the market is segmented into Diagnostic Applications Pharmaceutical Applications, Food Testing, Beverage Testing, Cosmetics and Personal Care Products Testing, Environmental Applications, and Other Applications. Based on End User, the market is segmented into Hospitals, Diagnostic Laboratories, and Blood Banks, Pharmaceutical Companies & Contract Research Organizations, Food Manufacturing Companies, Beverage Manufacturing Companies, and Other End Users. Based on region, the market is segmented into North America, Europe, Asia Pacific, Latin America and Middle East & and Africa.
Driver of the Global Microbial Identification Market
The increasing incidence of foodborne illnesses and infections has heightened the emphasis on stringent food safety protocols. As a result, regulatory agencies are urging food producers and manufacturers to implement rigorous microbial testing standards and practices. This heightened focus on ensuring food safety is propelling market expansion within the food and beverage sector. Companies are becoming more vigilant in adopting comprehensive microbial identification techniques to meet these elevated safety demands, thus fostering innovation and growth in the global microbial identification market. The ongoing commitment to improving food safety measures continues to shape industry practices and drive market development.
Restraints in the Global Microbial Identification Market
The identification and characterization of microorganisms presents significant challenges that require specialized expertise and skills. This inherent complexity can deter many laboratories and healthcare providers from embracing advanced systems and technologies, particularly in areas with limited resources and inadequate technical training. Consequently, these issues can impede the expansion of the Global Microbial Identification market, as the lack of accessibility to advanced tools and the need for skilled personnel may hinder widespread adoption and utilization of innovation in the field. As a result, overcoming these barriers becomes essential for fostering growth and enhancing microbial identification practices.
Market Trends of the Global Microbial Identification Market
The global microbial identification market is witnessing a significant trend towards the adoption of rapid molecular diagnostics, propelled by advancements in technologies such as next-generation sequencing and polymerase chain reaction (PCR). This shift emphasizes the need for swift and accurate identification of pathogens, enabling healthcare providers to make timely and informed treatment decisions. These molecular techniques offer superior sensitivity and faster turnaround times compared to traditional culture-based methods, enhancing patient outcomes through early diagnosis. As healthcare continues to prioritize precision medicine and improve diagnostic efficiency, the demand for innovative microbial identification solutions is expected to increase significantly, transforming the market landscape.
Table of Contents
Introduction
- Objectives of the Study
- Definitions
- Market Scope
Research Methodology
- Information Procurement
- Secondary & Primary Data Sources
- Market Size Estimation
- Market Assumptions & Limitations
Executive Summary
- Market Overview Outlook
- Supply Demand Trend Analysis
- Segmental Opportunity Analysis
Market Dynamics & Outlook
- Market Dynamics
- Drivers
- Opportunities
- Restraints
- Challenges
- Porters Analysis
- Competitive rivalry
- Threat of Substitute Products
- Bargaining Power of Buyers
- Threat of New Entrants
- Bargaining Power of Suppliers
Key Market Insights
- Technology Analysis
- Value Chain Analysis
- Ecosystem of the Market
- Supply chain Analysis
- Case study Analysis
- Regulatory Landscape
- Innovation Matrix
- Top Investment Analysis
- Key Success Factor
- Degree of Competition
Microbial Identification Market by Product & Service
- Market Overview
- Instruments & Software
- Consumables
- Panels/Id Cards & Media
- Kits
- Other Consumables
- Services
Microbial Identification Market by Method
- Market Overview
- Phenotypic Methods
- Proteomics-Based Methods
- Genotypic Methods
Microbial Identification Market by Technology
- Market Overview
- Mass Spectrometry-Based Microbial Identification Market
- PCR Based Microbial Identification Market
- Flow Cytometry Based Microbial Identification Market
- Microscopy Based Microbial Identification Market
- Other Microbial Identification Technologies
Microbial Identification Market by Application
- Market Overview
- Diagnostic Applications
- Human Disease Diagnosis
- Animal Disease Diagnosis
- Pharmaceutical Applications
- Food Testing
- Beverage Testing
- Cosmetics And Personal Care Products Testing
- Environmental Applications
- Other Applications
Microbial Identification Market, By End User
- Hospitals, Diagnostic Laboratories, and Blood Banks
- Pharmaceutical Companies & Contract Research Organizations
- Food Manufacturing Companies
- Beverage Manufacturing Companies
- Other End Users
Microbial Identification Market Market Size by Region
- Market Overview
- North America
- USA
- Canada
- Europe
- Germany
- Spain
- France
- UK
- Italy
- Rest of Europe
- Asia Pacific
- China
- India
- Japan
- South Korea
- Rest of Asia-Pacific
- Latin America
- Brazil
- Rest of Latin America
- Middle East & Africa (MEA)
- GCC Countries
- South Africa
- Rest of MEA
Competitive Landscape
- Top 5 Player Comparison
- Market Positioning of Key Players, 2025
- Strategies Adopted by Key Market Players
- Recent Activities in the Market
- Key Companies Market Share (%), 2025
Key Company Profiles
- BioMerieux SA (France)
- Company Overview
- Business Segment Overview
- Financial Updates
- Key Developments
- Becton, Dickinson and Company (BD) (US)
- Company Overview
- Business Segment Overview
- Financial Updates
- Key Developments
- Thermo Fisher Scientific Inc. (US)
- Company Overview
- Business Segment Overview
- Financial Updates
- Key Developments
- Danaher Corporation (US)
- Company Overview
- Business Segment Overview
- Financial Updates
- Key Developments
- Merck KGaA (Germany)
- Company Overview
- Business Segment Overview
- Financial Updates
- Key Developments
- Bruker Corporation (US)
- Company Overview
- Business Segment Overview
- Financial Updates
- Key Developments
- Shimadzu Corporation (Japan)
- Company Overview
- Business Segment Overview
- Financial Updates
- Key Developments
- Qiagen NV (Netherlands)
- Company Overview
- Business Segment Overview
- Financial Updates
- Key Developments
- Avantor, Inc. (US)
- Company Overview
- Business Segment Overview
- Financial Updates
- Key Developments
- Accelerate Diagnostics, Inc. (US)
- Company Overview
- Business Segment Overview
- Financial Updates
- Key Developments
- Biolog, Inc. (US)
- Company Overview
- Business Segment Overview
- Financial Updates
- Key Developments
- Liofilchem S.r.l. (Italy)
- Company Overview
- Business Segment Overview
- Financial Updates
- Key Developments
- Trivitron Healthcare (India)
- Company Overview
- Business Segment Overview
- Financial Updates
- Key Developments
- Gradian Diagnostics (US)
- Company Overview
- Business Segment Overview
- Financial Updates
- Key Developments
- Alifax S.r.l. (Italy)
- Company Overview
- Business Segment Overview
- Financial Updates
- Key Developments
- HiMedia Laboratories (India)
- Company Overview
- Business Segment Overview
- Financial Updates
- Key Developments
- i2a SA (France)
- Company Overview
- Business Segment Overview
- Financial Updates
- Key Developments
- Zhuhai DL Biotech Co., Ltd. (China)
- Company Overview
- Business Segment Overview
- Financial Updates
- Key Developments
- GeneFluidics, Inc. (US)
- Company Overview
- Business Segment Overview
- Financial Updates
- Key Developments
- Creative Diagnostics (US)
- Company Overview
- Business Segment Overview
- Financial Updates
- Key Developments





